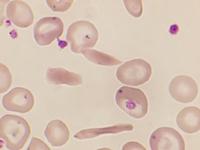

|
|
Sichelzellkrankheit
Sichelzellanämie, Drepanozytose
Autor/en: F.-G. Hagmann
Institution/en: Westpfalz-Klinikum, Kaiserslautern
Serie zuletzt geändert am: 26.10.2011
Neben unspezifischen Veränderungen der Erythrozyten (Anisozytose, Poikilozytose, Polychromasie, Targetzellen u.a.) finden sich die charakteristischen Sichelzellen. Diese sind typischerweise sichelförmig, können aber auch andere gestreckte Formen bilden (bananenförmig, schiffchenartig, sägeblattartig, erbsenschotenartig, lang elliptisch, torquiert, fragmentiert, bizarr). Aufgrund der Binnenstrukturveränderung der Zelle färben die Sichelzellen tiefer an. Jolly-Körper können vorkommen, wenn eine Splenektomie durchgeführt wurde, oder wenn es durch Milzatrophie zu einer funktionellen Asplenie kommt. Die Anzahl der Sichelzellen kann in einer stabilen Phase gering sein, bei Krisen (z.B. Infarkten oder Infektionen) ist sie erhöht. Durch einen Test (Sauerstoffentzug von Nativblut unter einem Deckglas auf dem Objektträger) kann die Sichelung provoziert werden.
Elektronenoptisch lassen sich die Erythrozytenformveränderungen bei Sichelzellanämie besonders plastisch darstellen. Das spielt aber für die Diagnostik keine Rolle.
Literaturreferenzen:
-
Kohne E. Hemoglobinopathies: clinical manifestations, diagnosis, and
treatment. Dtsch Arztebl Int 2011, 108(31-32). 532-40.
[Online]
-
Bessis M. Corpuscules. Essai sur la forme des globules rouges de l’homme, Springer International, Berlin, 1976.
-
Hann IM, et al. Colour Atlas of Paediatric Haematology, Second Edition. Oxford University Press, Oxford, 1990.
-
Hoffbrand AV, Pettit JE. Clinical haematology illustrated, Churchill Livingstone, Edinburgh, 1987.
-
Kapff CT, Jandl JH. Le sang. Atlas commenté d’hématologie, Médecine et Sciences Internationales, Paris, 1982.
-
Begemann H, Rastetter J. Klinische Hämatologie, 4. Auflage. Georg Thieme Verlag, Stuttgart, 1993.
[DNB]
-
Varet B. Le livre de l’interne. Hématologie, Médecine-Sciences Flammarion, Paris, 1997.
-
Dickerhoff R, et al. Sichelzellerkrankungen in Deutschland. Dt Ärztebl 1998;95:1348-1353(B).
-
Schub H, Antoni DH. 29-jähriger Senegalese mit akuten thorakalen Beschwerden und starken Schulterschmerzen. Internist 1993;34:858-861.
[Medline]
|

 Zum Seitenanfang Zum Seitenanfang
 Sitemap
| Sitemap
|  |
| 
|
Anämie und Polyglobulie Der Hämatologische Notfall. Sysmex Kalender 2008 [ Mehr] Der Hämatologische Notfall. Sysmex Kalender 2008 [ Mehr] |
|